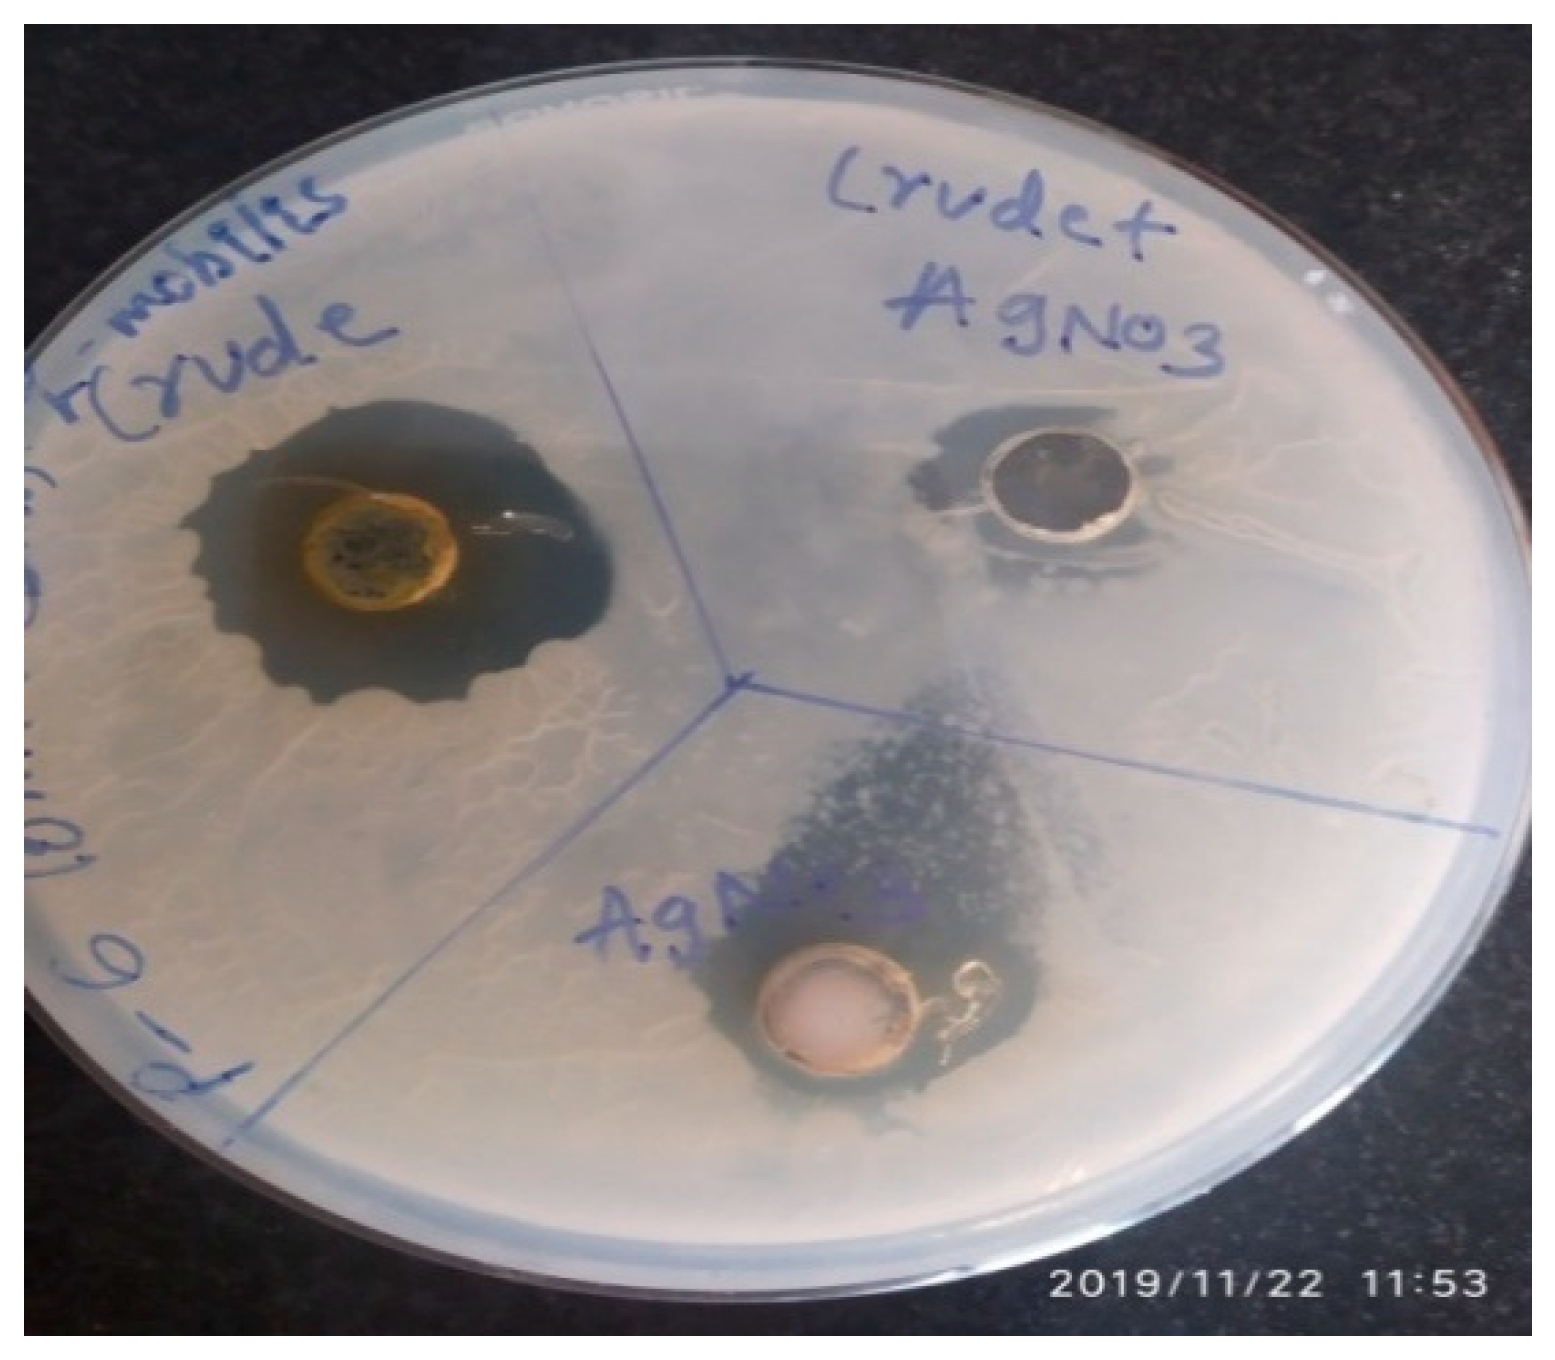
Molecules 27 02715 g006

Characterization of Bioactive Compounds from Acacia concinna and Citrus limon, Silver Nanoparticles’ Production by A. concinna Extract, and Their Biological Properties
Abstract
:1. Introduction
2. Materials and Methods
2.1. Plants, Microorganisms, Cell Lines, and Chemicals
2.2. Extraction and Quantification of the Phytochemicals
2.3. Identification of Functionally Organic Groups in the Phytochemicals
2.4. Antibacterial Action of A. concinna and C. limon Extracts
2.4.1. Antibacterial Activity Studies and Minimum Inhibitory Concentration (MIC) Investigations
2.4.2. Partial Purification of Bioactive Compounds and Antimicrobial Activity for Protein Fractions
2.4.3. Silver Nanoparticles’ Production by A. concinna Extract
2.5. Anticancer Activity of A. concinna Extract and C. limon Extracts
2.6. Antioxidant Activity of A. concinna and C. limon Extracts
2.7. Enzyme Inhibition Investigations
2.7.1. α-Amylase and α-Glucosidase Inhibitions by A. concinna and C. limon Extracts
2.7.2. In Vitro Lipase Activity Inhibition by A. concinna and C. limon Extracts
2.7.3. In Vitro Urease Activity Inhibition by A. concinna and C. limon Extracts
2.8. Inhibition Kinetics Studies of Amylase, Glycosidase, and Urease
2.9. Statistical Analysis of Data
3. Results and Discussion
3.1. Screening of Phytochemicals
3.2. Identification of Functionally Organic Groups in the Phytochemicals
3.2.1. FTIRS Analysis of A. concinna and C. limon Extracts
3.2.2. Determination of Quercetin from A. concinna Extract
3.2.3. Determination of Compounds from Plant C. limon Extract
3.3. Antibacterial Activity of A. concinna and C. limon Extracts and Determination of Minimum Inhibitory Concentration
3.4. Partial Purification of Bioactive Compounds and Antimicrobial Activity for Protein Fractions
3.5. Synthesis of Silver Nanoparticles and Antimicrobial Activity of A. concinna
3.6. Anticancer Activity of A. concinna and C. limon Extracts
3.7. Antioxidant Effect of A. concinna and C. limon Extracts
3.8. Enzyme Inhibition Activities
3.8.1. α-Amylase and α-Glucosidase Inhibition by A. concinna and C. limon Extracts
3.8.2. In Vitro Lipase Activity Inhibition by A. concinna and C. limon Extracts
3.8.3. In Vitro Urease Activity Inhibition by A. concinna and C. limon Extracts
3.9. Inhibition Kinetics Studies of Amylase, Glycosidase, and Urease
4. Conclusions
Author Contributions
Funding
Institutional Review Board Statement
Informed Consent Statement
Data Availability Statement
Acknowledgments
Conflicts of Interest
Sample Availability
References
- Zhang, L.; Tu, Z.C.; Xie, X.; Lu, Y.; Wang, Z.X.; Wang, H.; Sha, X.M. Antihyperglycemic, antioxidant activities of two Acer palmatum cultivars, and identification of phenolics profile by UPLC-QTOFMS/MS: New natural sources of functional constituents. Ind. Crops Prod. 2016, 89, 522–532. [Google Scholar] [CrossRef]
- Kabera, J.N.; Semana, E.; Mussa, A.R.; He, X. Plant Secondary Metabolites: Biosynthesis, Classification, Function and Pharmacological Properties. J. Pharm. Pharmacol. 2014, 2, 377–383. [Google Scholar]
- Zeng, S.L.; Li, S.Z.; Wei, M.Y.; Chen, B.Z.; Li, P.; Zheng, G.D.; Liu, E.H. Evaluation of anti-lipase activity and bioactive flavonoids in the citri reticulatae pericarpium from different harvest time. Phytomedicine 2018, 43, 103–109. [Google Scholar] [CrossRef] [PubMed]
- Jain, C.; Khatana, S. Rekha Vijayvergia Bioactivity of secondary metabolites of various plants: A review. Int. J. Pharm. Sci. Res. 2019, 10, 494–504. [Google Scholar] [CrossRef]
- Alo, M.N.; Anyim, C.; Igwe, J.C.; Elom, M.; Uchenna, D.S. Antibacterial activity of water, ethanol and methanol extracts of Ocimumgratissimum, Vernoniaamygdalina and Aframomummelegueta. Adv. Appl. Sci. Res. 2012, 3, 844–848. [Google Scholar]
- Khoja, K.K.; Shaf, G.; Hasan, T.N.; Syed, N.A.; Al-Khalifa, A.S.; Al-Assaf, A.H.; Alshatwi, A.A. Fenugreek, a naturally occurring edible spice, kills MCF-7 human breast cancer cells via an apoptotic pathway. Asian Pac. J. Cancer Prev. 2011, 12, 3299–3304. [Google Scholar]
- You, Q.; Chen, F.; Wang, X.; Jiang, Y.; Lin, S. Antidiabetic activities of phenolic compounds in muscadine against alpha-glucosidase and pancreatic lipase. Food Sci. Technol. 2012, 46, 164–168. [Google Scholar]
- Singh, A.; Nautiyal, M.C.; Kunwar, R.M.; Bussmann, R.W. Ethnomedicinal plants used by local inhabitants of Jakholi block, Rudraprayag district, western Himalaya, India. J. Ethnobiol. Ethnomed. 2017, 13, 49. [Google Scholar] [CrossRef] [Green Version]
- Tezuka, Y.; Honda, K.; Banskota, A.H.; Thet, M.M.; Kadota, S. Kinmoonosides A−C, Three New Cytotoxic Saponins from the Fruits of Acacia concinna, a Medicinal Plant Collected in Myanmar. J. Nat. Prod. 2000, 63, 1658–1664. [Google Scholar] [CrossRef]
- Naim, M.; Amjad, F.M.; Sultana, S.; Islam, S.N.; Hossain, M.A.; Begum, R.; Rashid, M.A.; Amran, M.S. Comparative Study of Antidiabetic Activity of Hexane-Extract of Lemon Peel (Limon citrus) and Glimepiride in Alloxan-Induced Diabetic Rats. Bangladesh Pharm. J. 2012, 15, 131–134. [Google Scholar] [CrossRef]
- Ogbulie, J.N.; Ogueke, C.C.; Nwanebu, F.C. Antibacterial properties of Uvaria chamae, Congronema latifolium, Garcinia kola, Vemonia amygdalina and Aframomium melegueta. Afr. J. Biotechnol. 2007, 6, 1549–1553. [Google Scholar]
- Jeong, J.Y.; Jo, Y.H.; Lee, K.Y.; Do, S.G.; Hwang, B.Y.; Lee, M.K. Optimization of pancreatic lipase inhibition by Cudrania tricuspidata fruits using response surface methodology. Bioorganic Med. Chem. Lett. 2014, 24, 2329–2333. [Google Scholar] [CrossRef] [PubMed]
- Khan, A.W.; Jan, S.; Parveen, S.; Khan, R.A.; Saeed, A.; Tanveer, A.J.; Shad, A.A. Phytochemical analysis and Enzyme Inhibition Assay of Aerva javanica for Ulcer. Chem. Cent. J. 2012, 6, 76. [Google Scholar] [CrossRef] [Green Version]
- David, B.C.; Sudarsanam, G. Antimicrobial activity of Gymnema sylvestre (Asclepiadaceae). J. Acute Dis. 2013, 2, 222–225. [Google Scholar] [CrossRef] [Green Version]
- Chakraborty, D.; Shah, B. Antimicrobial, antioxidative and antihemolytic activity of Piper betel leaf extracts. Int. J. Pharm. Pharm. Sci. 2011, 3, 192–199. [Google Scholar]
- Muhsinah, A.B.; Maqbul, M.S.; Mahnashi, M.H.; Jalal, M.M.; Altayar, M.A.; Saeedi, N.H.; Alshehri, O.M.; Shaikh, I.A.; Khan, A.A.L.; Shakeel Iqubal, S.M.; et al. Antibacterial Activity of Illicium Verum Essential Oil against MRSA Clinical Isolates and Determination of Its Phyto-Chemical Components. J. King Saud Univ. Sci. 2022, 34, 101800. [Google Scholar] [CrossRef]
- Pascale, R.; Bianco, G.; Cataldi, T.R.I.; Kopplin, P.S.; Bosco, F.; Vignola, L.; Uhl, J.; Lucio, M.; Milell, L. Mass spectrometry-based phytochemical screening for hypoglycemic activity of Fagioli di Sarconi beans (Phaseolus vulgaris L.). Food Chem. 2018, 242, 497–504. [Google Scholar] [CrossRef] [Green Version]
- Bagewadi, Z.K.; Muddapur, U.M.; Madiwal, S.S.; Mulla, S.I.; Khan, A. Biochemical and enzyme inhibitory attributes of methanolic leaf extract of Datura inoxia Mill. Environ. Sustain. 2019, 2, 75–87. [Google Scholar] [CrossRef]
- Bagewadi, Z.K.; Mulla, S.I.; Ninnekar, H.Z. Purification and characterization of endo β-1,4-D-glucanase from Trichoderma harzianum strain HZN11 and its application in production of bioethanol from sweet sorghum bagasse. 3 Biotech 2016, 6, 101. [Google Scholar] [CrossRef] [Green Version]
- Sundararajan, M.; Thomas, P.A.; Babyshalini, K.; Geraldine, P. Identification of phytoconstituents and in-vitro evaluation of the putative anticataractogenic effect of an ethanolic root extract of Leucas aspera. Biomed. Pharmacother. 2017, 85, 87–101. [Google Scholar] [CrossRef]
- Tandon, C.; Mathur, P.; Sen, M.; Kanojiya, S. Identification of an antibacterial withanolide (dinoxin b) from leaf of Datura inoxia mill. Int. J. Phytomed. 2016, 8, 1–12. [Google Scholar]
- Arulvasu, C.; Shiva Shakthi, S.K.; Babu, G.; Radhakrishnan, N. Purification and identification of bioactive protein from leaves of Datura inoxia P.mil. Biomed. Prev. Nutr. 2014, 4, 143–149. [Google Scholar] [CrossRef]
- Lowry, O.H.; Rosenberg, W.J.; Farr, A.L.; Randell, R.J. Quantitation of protein using Folin Ciocalteu reagent. J. Biol. Chem. 1951, 193, 265–275. [Google Scholar] [CrossRef]
- Ighodaro, O.M.; Akinloye, O.A.; Ugbaja, R.N.; Omotainse, S.O.; Faokunla, O. FT-IR analysis of Sapium ellipticum (Hochst) pax ethanol leaf extract and its inhibitory effects on pancreatic α-amylase and intestinal α-glucosidase activities in vitro. Egypt. J. Basic Appl. Sci. 2016, 3, 343–349. [Google Scholar] [CrossRef] [Green Version]
- Taskin, T.; Taskin, D. In vitro anti-urease, antioxidant activities and phytochemical composition of Geranium purpureum. J. Food Meas. Charact. 2017, 11, 2102–2109. [Google Scholar] [CrossRef]
- Lineweaver, H.; Burk, D. The determination of enzyme dissociation constants. J. Am. Chem. Soc. 1934, 56, 658–666. [Google Scholar] [CrossRef]
- Hegazy, A.E.; Ibrahium, M.I. Antioxidant activities of orange peel extracts. World Appl. Sci. J. 2012, 18, 684–688. [Google Scholar]
- Pelczar, M.J.; Chan, E.C.S.; Kreig, N.R. Microbiology; Tata McGrow-Hill: New Delhi, India, 1993; Volume 5. [Google Scholar]
- Diab, K.A.E. In Vitro Studies on Phytochemical Content, Antioxidant, Anticancer Immunomodulatory and Antigenotoxic Activities of Lemon, Grapefruit, and Mandarin Citrus Peels. Asian Pac. J. Cancer Prev. 2016, 17, 3559–3567. [Google Scholar]
- Umuhoza, M.R.; Habyarimana, T.; Niyonzima, F.N. Activity of Kalanchoe integra against selected pathogenic bacteria. Open Access J. Microbiol. Biotechnol. 2021, 6, 1–6. [Google Scholar] [CrossRef]
- Uysal, S.; Aumeeruddy-Elalfi, Z.; Zengin, G.; Aktumsek, A.; Mocan, A.; Custodio, L.; Neng, N.R.; Nogueira, J.M.F.; Ćirić, A.; Glamočlija, J.; et al. Insight into the biological properties and phytochemical composition of Ballota macrodonta Boiss. et Balansa—An endemic medicinal plant from Turkey. Ind. Crops Prod. 2018, 113, 422–428. [Google Scholar] [CrossRef]
- Iqbal, N.; Iqubal, S.M.S.; Khan, A.A.; Mohammed, T.; Alshabi, A.M.; Aazam, E.S.; Rafiquee, M.Z.A. Effect of CTABr (Surfactant) on the Kinetics of Formation of Silver Nanoparticles by Amla Extract. J. Mol. Liq. 2021, 329, 115537. [Google Scholar] [CrossRef]
- Muddapur, U.M.; Alshehri, S.; Ghoneim, M.M.; Mahnashi, M.H.; Alshahrani, M.A.; Khan, A.A.; Iqubal, S.M.S.; Bahafi, A.; More, S.S.; Shaikh, I.A.; et al. Plant-Based Synthesis of Gold Nanoparticles and Theranostic Applications: A Review. Molecules 2022, 27, 1391. [Google Scholar] [CrossRef] [PubMed]
- Mousavi-Kouhi, S.M.; Beyk-Khormizi, A.; Amiri, M.S.; Mashreghi, M.; Yazdi, M.E.T. Silver-zinc oxide nanocomposite: From synthesis to antimicrobial and anticancer properties. Ceram. Int. 2021, 47, 21490–21497. [Google Scholar] [CrossRef]
- Yazdi, M.E.T.; Nourbakhsh, F.; Mashreghi, M.; Mousavi, S.H. Ultrasound-based synthesis of ZnO·Ag2O3 nanocomposite: Characterization and evaluation of its antimicrobial and anticancer properties. Res. Chem. Intermed. 2021, 47, 1285–1296. [Google Scholar] [CrossRef]
- Khan, S.A.; Shahid, S.; Lee, C.-S. Green Synthesis of Gold and Silver Nanoparticles Using Leaf Extract of Clerodendrum inerme; Characterization, Antimicrobial, and Antioxidant Activities. Biomolecules 2020, 10, 835. [Google Scholar] [CrossRef]
- Yazdi, M.T.; Nazarnezhad, S.; Mousavi, S.; Amiri, M.S.; Darroudi, M.; Baino, F.; Kargozar, S. Gum Tragacanth (GT): A Versatile Biocompatible Material beyond Borders. Molecules 2021, 26, 1510. [Google Scholar] [CrossRef] [PubMed]
- Jaikumar, B.; Jasmine, R. A review on a few medicinal plants possessing anticancer activity against human breast cancer. Int. J. Pharm. Tech. Res. 2016, 9, 333–365. [Google Scholar]
- Zhang, L.; Zhu, M.F.; Tu, Z.C.; Zhao, Y.; Wang, H.; Li, G.J.; Sha, X.M. a-Glucosidase inhibition, anti-glycation and antioxidant activities of Liquidambar formosana Hance leaf, and identification of phytochemical profile. S. Afr. J. Bot. 2017, 113, 239–247. [Google Scholar] [CrossRef]
- Rai, V.; Pai, V.R.; Kedilaya, P. A preliminary evaluation of anticancer and antioxidant potential of two traditional medicinal plants from Lamiaceae-Pogostemonheyneanus and Plectranthusamboinicus. J. Appl. Pharm. Sci. 2016, 6, 74–79. [Google Scholar]
- Vermillion, K.; Holguin, F.O.; Berhow, M.A.; Richins, R.D.; Redhouse, T.; O’Connell, M.A.; Posakony, J.; Mahajan, S.S.; Kelly, S.M.; Simon, J.A. Dinoxin B, a withanolide from Datura inoxia leaves with specific cytotoxic activities. J. Nat. Prod. 2011, 74, 267–271. [Google Scholar] [CrossRef] [Green Version]
- Fatima, H.; Khan, K.; Zia, M.; Ur-Rehman, T.; Mirza, B.; Haq, I.U. Extraction optimization of medicinally important metabolites from Datura innoxia Mill.: An in vitro biological and phytochemical investigation. BMC Complement. Altern. Med. 2015, 15, 376. [Google Scholar] [CrossRef] [PubMed] [Green Version]
- Shah, N.A.; Khan, M.R.; Sattar, S.; Ahmad, B.; Mirza, B. HPLC-DAD analysis, antioxidant potential and anti-urease activity of Asparagus gracilis collected from district Islamabad. BMC Complement. Altern. Med. 2014, 14, 347. [Google Scholar] [CrossRef] [PubMed] [Green Version]

| Phytoconstituents | A. concinna | C. limon |
|---|---|---|
| Alkaloids | + | + |
| Flavonoids | + | + |
| Saponins | + | + |
| Steroids and triterpenoids | + | + |
| Tannins | + | + |
| Phenols | + | + |
| Glycosides | + | + |
| Quinones | + | + |
| Coumarins | + | + |
| Diterpenes | − | + |
| Phlobatannins | + | + |
| Anthocyanosides | + | + |
| Catechins | − | − |
| Medicinal Plant | Alkaloids (mg/L) | Flavonoids (mg/L) | Phenols (mg/L) |
|---|---|---|---|
| A. concinna | 0.1860 ± 0.0001 | 0.2768 ± 0.0003 | 0.2431 ± 0.0002 |
| C. limon | 0.0002 ± 0.0000 | 0.1752 ± 0.0001 | 0.3401 ± 0.0007 |
| Medicinal Plant | E. coli | B. subtilis | Z. mobilis | M. luteus | S. aureus | B. cereus | P. aeruginosa |
|---|---|---|---|---|---|---|---|
| A. concinna | 22 ± 0.763 | 7 ± 0.123 | 24 ± 0.801 | 7 ± 0.285 | 20 ± 0.365 | 5 ± 0.169 | 5 ± 0.401 |
| C. limon | 22 ± 0.671 | 17 ± 0.249 | 22 ± 0.593 | 32 ± 0.582 | 27 ± 0.801 | 22 ± 0.467 | 21 ± 0.397 |
| A. concinna | E. coli | B. subtilis | Z. mobilis | M. luteus | S. aureus | P. aeruginosa |
| 50 µg/mL | − | − | − | − | − | − |
| 100 µg/mL | − | − | − | − | − | − |
| 150 µg/mL | − | − | − | − | − | − |
| C. limon | ||||||
| 50 µg/mL | + | − | − | + | − | − |
| 100 µg/mL | − | − | − | − | − | − |
| 150 µg/mL | − | − | − | − | − | − |
| Blank | Untreated | Cisplatin 15 µg/mL | 100 | 200 | 300 | 400 | 500 µg/mL | |
|---|---|---|---|---|---|---|---|---|
| Reading 1 | 0.009 | 0.63 | 0.068 | 0.375 | 0.229 | 0.19 | 0.011 | 0.007 |
| Reading 2 | 0.005 | 0.69 | 0.068 | 0.387 | 0.202 | 0.172 | 0.017 | 0.009 |
| Mean OD | 0.007 | 0.685 | 0.068 | 0.381 | 0.2155 | 0.181 | 0.014 | 0.008 |
| Mean OD-Mean blank | 0.678 | 0.0681 | 0.374 | 0.2085 | 0.174 | 0.007 | 0.001 | |
| Standard deviation | 0.0169706 | 0 | 0.008485 | 0.019092 | 0.012728 | 0.004243 | 0.001414 | |
| Standard Error | 0.012 | 0 | 0.006 | 0.0135 | 0.009 | 0.003 | 0.001 | |
| % Standard error | 1.7699115 | 0 | 0.884956 | 1.99115 | 1.327434 | 0.442478 | 0.1474 | |
| % Viability | 100 | 8.997050 | 55.16224 | 30.75221 | 25.66372 | 1.032448 | 0.147493 |
| Blank | Untreated | Cisplatin 15 µg/mL | 100 µg/mL | 200 µg/mL | 300 µg/mL | 400 µg/mL | 500 µg/mL | |
|---|---|---|---|---|---|---|---|---|
| Reading 1 | 0.009 | 0.63 | 0.068 | 0.365 | 0.21 | 0.194 | 0.02 | 0.008 |
| Reading 2 | 0.005 | 0.69 | 0.068 | 0.367 | 0.204 | 0.182 | 0.022 | 0.007 |
| Mean OD | 0.007 | 0.66 | 0.068 | 0.366 | 0.207 | 0.188 | 0.021 | 0.007 |
| Mean OD-Mean blank | 0.653 | 0.061 | 0.359 | 0.2 | 0.181 | 0.014 | 0.0005 | |
| Standard deviation | 0.04 | 0 | 0.001 | 0.004 | 0.008 | 0.001 | 0 | |
| Standard Error | 0.03 | 0 | 0.001 | 0.003 | 0.006 | 0.001 | 0.0005 | |
| % Standard error | 4.59 | 0 | 0.15 | 0.45 | 0.91 | 0.15 | 0.07 | |
| % Viability | 100 | 9.34 | 54.97 | 30.62 | 27.71 | 2.14 | 0.076 |
Publisher’s Note: MDPI stays neutral with regard to jurisdictional claims in published maps and institutional affiliations. |
© 2022 by the authors. Licensee MDPI, Basel, Switzerland. This article is an open access article distributed under the terms and conditions of the Creative Commons Attribution (CC BY) license (https://creativecommons.org/licenses/by/4.0/).
Share and Cite
Shaikh, I.A.; Muddapur, U.M.; Bagewadi, Z.K.; Chiniwal, S.; Ghoneim, M.M.; Mahnashi, M.H.; Alsaikhan, F.; Yaraguppi, D.; Niyonzima, F.N.; More, S.S.; et al. Characterization of Bioactive Compounds from Acacia concinna and Citrus limon, Silver Nanoparticles’ Production by A. concinna Extract, and Their Biological Properties. Molecules 2022, 27, 2715. https://doi.org/10.3390/molecules27092715
Shaikh IA, Muddapur UM, Bagewadi ZK, Chiniwal S, Ghoneim MM, Mahnashi MH, Alsaikhan F, Yaraguppi D, Niyonzima FN, More SS, et al. Characterization of Bioactive Compounds from Acacia concinna and Citrus limon, Silver Nanoparticles’ Production by A. concinna Extract, and Their Biological Properties. Molecules. 2022; 27(9):2715. https://doi.org/10.3390/molecules27092715
Chicago/Turabian StyleShaikh, Ibrahim Ahmed, Uday M. Muddapur, Zabin K. Bagewadi, Sneha Chiniwal, Mohammed M. Ghoneim, Mater H. Mahnashi, Fahad Alsaikhan, Deepak Yaraguppi, Francois N. Niyonzima, Sunil S. More, and et al. 2022. "Characterization of Bioactive Compounds from Acacia concinna and Citrus limon, Silver Nanoparticles’ Production by A. concinna Extract, and Their Biological Properties" Molecules 27, no. 9: 2715. https://doi.org/10.3390/molecules27092715
APA StyleShaikh, I. A., Muddapur, U. M., Bagewadi, Z. K., Chiniwal, S., Ghoneim, M. M., Mahnashi, M. H., Alsaikhan, F., Yaraguppi, D., Niyonzima, F. N., More, S. S., Mannasaheb, B. A., Al Ali, A., Asiri, A., Khan, A. A., & Iqubal, S. M. S. (2022). Characterization of Bioactive Compounds from Acacia concinna and Citrus limon, Silver Nanoparticles’ Production by A. concinna Extract, and Their Biological Properties. Molecules, 27(9), 2715. https://doi.org/10.3390/molecules27092715








